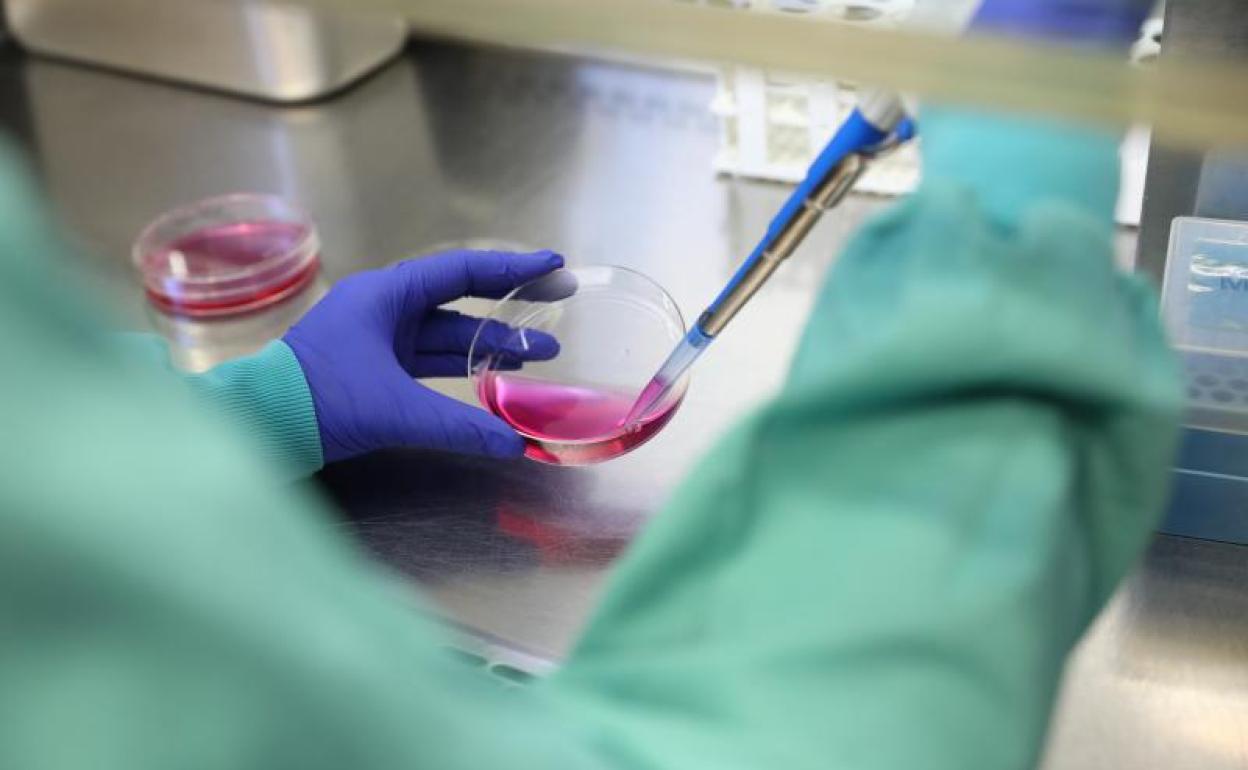
Una bióloga trabaja en un laboratorio

Una compañía de EE UU prueba una vacuna para Covid-19 en Australia
La empresa comenzará a producir la vacuna antes de saber los resultados definitivos, para que si son positivos pueda estar disponible cuanto antes
EP
Madrid
Martes, 26 de mayo 2020, 08:43
La empresa de biotechnology estadounidense Novavax ha anunciado el inicio de los ensayos clínicos de una vacuna experimental contar el coronavirus en 130 personas, con lo que son ya 10 los proyectos en marcha con ensayos en humanos.
Este mismo lunes será vacunado el primer individuo en Australia. Las pruebas de la vacuna, denominada NVX-CoV2373, se desarrollan en Australia en dos ubicaciones distintas, informa la televisión australiana CNN.
La vacuna ha logrado altos niveles de anticuerpos en las pruebas previas, según un comunicado de la empresa difundido este lunes. «Estos resultados dan pruebas sólidas de que la vacuna candidata será altamente inmunogénica en humanos, con lo que protegerá de la COVID-19 y ayudará a controlar el contagio de esta enfermedad», indica Novavax.
Noticia Relacionada
Directo | Así avanza la lucha contra el coronavirus
El anuncio ha sido realizado directamente en nota de prensa, sin que se haya publicado en ninguna revista científica y sin ser validados sus datos independientemente.
La empresa espera tener los resultados del ensayo clínico en julio, con lo que podría pasar a una segunda fase de ensayos con una población más amplia y en distintos países del mundo para evaluar la seguridad y eficacia de la vacuna.
En cualquier caso la empresa comenzará a producir la vacuna antes de saber los resultados definitivos, para que si son positivos pueda estar disponible cuanto antes. La fabricación cuenta con una inyección de 388 millones de dólares de la Coalición para la Preparación para las Innovaciones Epidémicas (CEPI, por sus siglas en inglés), una organización público-privada.
Desde la empresa han asegurado a la CNN que habrá 100 millones de dosis de la vacuna para finales de año y 1.000 millones para el año 2021.
.